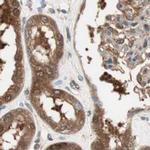
GALT Antibody in Immunohistochemistry (IHC)

Search
Invitrogen
GALT Polyclonal Antibody
{{$productOrderCtrl.translations['antibody.pdp.commerceCard.promotion.promotions']}}
{{$productOrderCtrl.translations['antibody.pdp.commerceCard.promotion.viewpromo']}}
{{$productOrderCtrl.translations['antibody.pdp.commerceCard.promotion.promocode']}}: {{promo.promoCode}} {{promo.promoTitle}} {{promo.promoDescription}}. {{$productOrderCtrl.translations['antibody.pdp.commerceCard.promotion.learnmore']}}
产品信息
PA5-52195
种属反应
宿主/亚型
分类
类型
抗原
偶联物
形式
浓度
规格
纯化类型
保存液
内含物
保存条件
运输条件
RRID
产品详细信息
Immunogen sequence: SEHWLVLVPF WATWPYQTLL LPRRHVRRLP ELTPAERDDL ASIMKKLLTK YDNLFETSFP YSMGWHGAPT GSEAGANWNH WQLHAHYYPP LLRSATVRKF MVGYEMLAQA QRDLTPEQAA ERLRALPEVH YHLGQKDRET A
Highest antigen sequence identity to the following orthologs: Mouse - 91%, Rat - 88%.
靶标信息
Galactose-1-phosphate uridyl transferase (GALT) catalyzes the second step of the Leloir pathway of galactose metabolism, namely the conversion of UDP-glucose + galactose-1-phosphate to glucose-1-phosphate + UDP-galactose. The absence of this enzyme results in classic galactosemia in humans and can be fatal in the newborn period if lactose is not removed from the diet. The pathophysiology of galactosemia has not been clearly defined.
仅用于科研。不用于诊断过程。未经明确授权不得转售。
篇参考文献 (0)
生物信息学
蛋白别名: Gal-1-P uridylyltransferase; galactose-1-phosphate uridyl transferase; Galactose-1-phosphate uridylyltransferase; UDP-glucose--hexose-1-phosphate uridylyltransferase; unnamed protein product
基因别名: GALT
UniProt ID: (Human) P07902
Entrez Gene ID: (Human) 2592